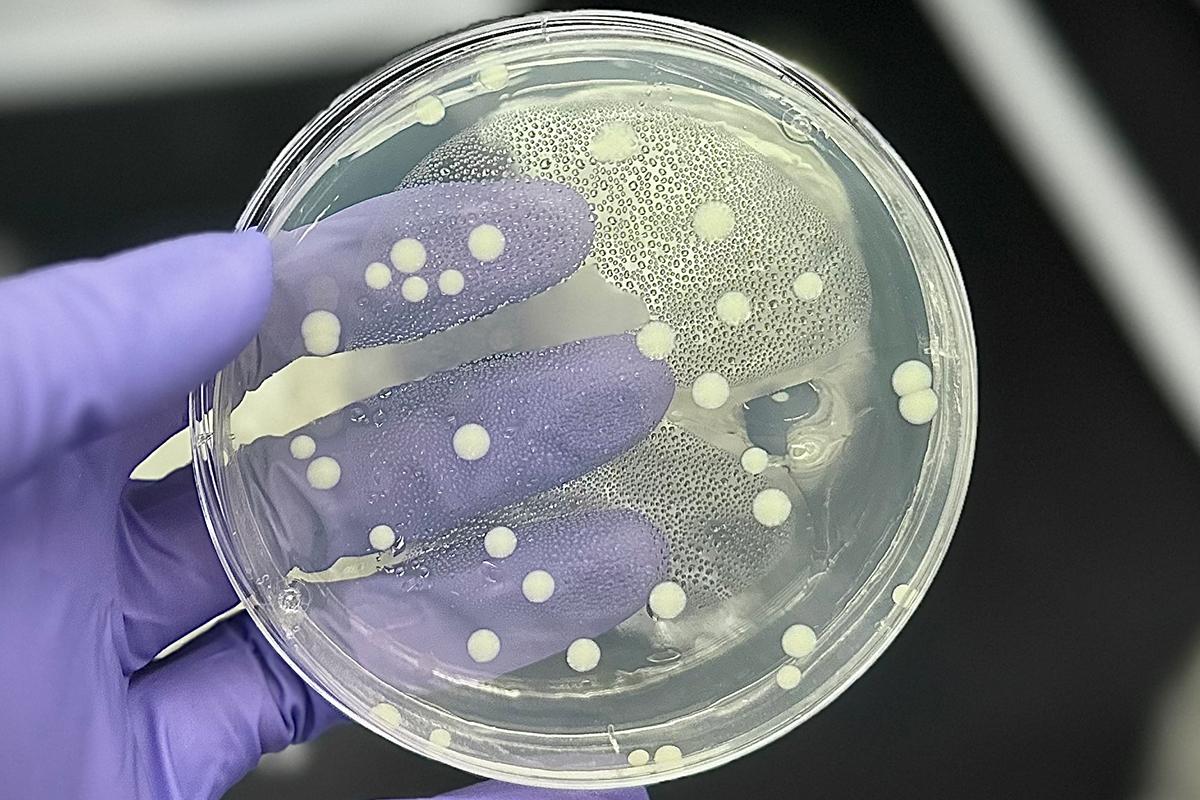
Bacteria inside a petri dish

Honours and Awards
The University of Guelph celebrates faculty achievements through prestigious awards and affiliations. Whether through national recognition by external bodies or internal awards highlighting outstanding contributions, these honours reflect the impact of our researchers across disciplines.
University of Guelph Awards

Research Excellence Awards
The University’s Research Excellence Awards recognize recently tenured faculty for outstanding contributions to research, training and knowledge mobilization. Sponsored by the Office of Research and the Office of the Provost, these $5,000 awards celebrate excellence across disciplines and elevate recipients’ visibility within the research community.

Research Leadership Chairs
Launched in 2017, U of G’s Research Leadership Chair program recognizes mid to late career faculty who have made significant contributions to their fields nationally and internationally. Each chair receives funding to support their work and the mentorship of future researchers.
National & Provincial Awards

Royal Society of Canada
The Royal Society of Canada (RSC) recognizes excellence in research, scholarship and the arts, bringing together over 3,700 distinguished members across its three academies: Arts and Humanities, Social Sciences and Science. Through its Fellows and Scholars, including faculty and researchers from the University of Guelph, the RSC mobilizes expertise to advance knowledge and engage with society.

Natural Science and Engineering Research Council Awards
The Natural Science and Engineering Research Council (NSERC) fosters innovation in natural sciences and engineering through grants and awards. Its Synergy Awards honour outstanding research partnerships, while the Donna Strickland Prize recognizes work with lasting societal impact, showcasing collaborations that transform research into real-world solutions.

Social Sciences and Humanities Research Council Awards
The Social Sciences and Humanities Research Council (SSHRC) supports and strengthens Canada’s knowledge culture across the social sciences and humanities. The Impact Awards celebrate outstanding researchers and recognize their achievements in research, training, knowledge mobilization and outreach, for work funded in whole or in part by SSHRC.

Killam Prize
The Killam Prize is one of Canada’s most prestigious research awards, recognizing exceptional career achievements across disciplines. It honours outstanding contributions through the National Killam Program and celebrates distinguished recipients making lasting impacts.

Canadian Academy of Health Sciences
Fellowship in the Canadian Academy of Health Sciences (CAHS) is one of Canada’s highest honours in health science. It recognizes leaders across biomedical, clinical, social and population health disciplines committed to advancing solutions for pressing health challenges.

Early Researcher Awards
The Early Researcher Awards (ERA) program supports promising Ontario faculty within their first 10 years by providing up to $100,000 in matched funding. It helps build research teams, advance innovative projects and train the next generation of talent across diverse disciplines.
Your Questions, Answered
Review frequently asked questions to guide your nomination or application.